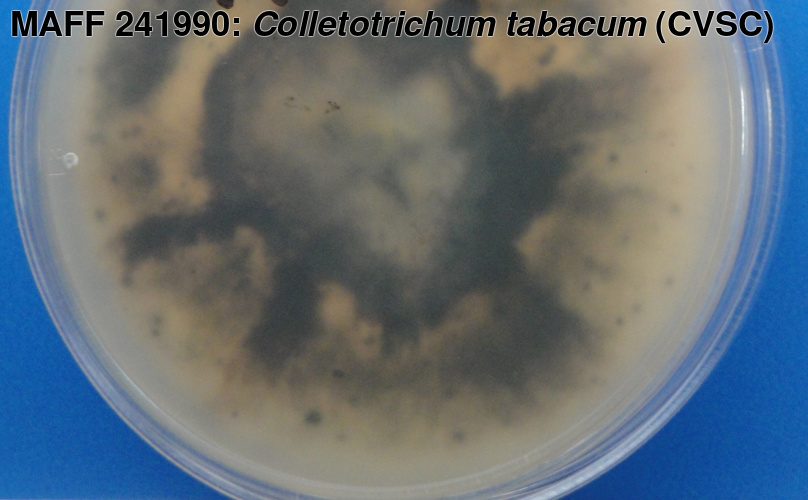
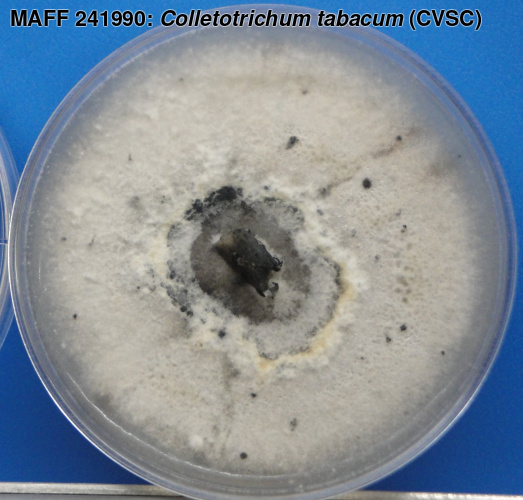

MAFF 241990の詳細
| MAFF番号 | 241990 |
|---|
| 微生物種類 | 糸状菌 |
|---|
| 学名 | Colletotrichum tabacum Boening (CVSC) |
|---|
| 再同定者 | 佐藤豊三 (更新: 2015/03) |
|---|
| 登録時学名 | Colletotrichum destructivum O'Gara |
|---|
| 同定者 | 下元祥史 |
|---|
| 分離源 | ミツバ |
|---|
| 分離部位 | 葉 |
|---|
| 採集地 | 高知 (高岡郡佐川町) |
|---|
| 採集日 | 2008/10 |
|---|
| 分離者 | 下元祥史 |
|---|
| 提供者 | 下元祥史 |
|---|
| 株名 | CJ1 |
|---|
| 培養適温 | 25℃ |
|---|
| 培養期間 | 10日 |
|---|
| 環境有害性 | 植物病原性 |
|---|
| 塩基配列 | Actin EF1-α GPDH ITS β-tubulin |
|---|
| 写真データ | |
|---|
| 配布申込 | 申込 |
|---|